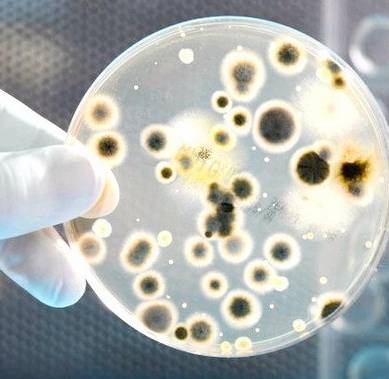
Image 1725

Урогенитальный трихомоноз, или трихомониаз вызывает влагалищная трихомонада (Trichomonas vaginalis). В большинстве случаев возбудитель проникает в человека половым путем, особенно – при случайных половых контактах. Известны случаи инфицирования через личные принадлежности, которые уже использовал ранее зараженный человек.
О возбудителе трихомоноза
Трихомонада – микроорганизм, относящийся к типу Простейших, способный ко всем основным жизненным видам организации: движению, размножению, обмену веществ, питанию и т.д. Форма микроба напоминает своим видом грушу, но постоянно меняется вследствие движения и встречи препятствий. Обычные размеры влагалищной трихомонады до 20 мкм, иногда попадаются особи до 35 мкм.
Обратите внимание: более крупные формы характерны для хронической стадии болезни.
Питается возбудитель болезни методом фагоцитоза. Размножение идет путем продольного или множественного деления. Трихомонада способна переходить в неподвижную стадию, устойчивую к неблагоприятным условиям внешней среды, так как активная форма очень чувствительна к изменениям температурных параметров обитания. Также губителен для микроба солнечный свет.
Химический состав среды (кислая, нейтральная, слабощелочная) переносится патогенным возбудителем хорошо.
Влагалищная трихомонада обитает в мочеполовой системе человека. При проникновении далеко не всегда вызывает клинические проявления заболевания, так как ей успешно противостоит иммунитет. В этом случае имеем дело с трихомонадоносительством.
Воспаление мочеиспускательного канала – трихомонозный уретрит, возникает при повышенной активности (вирулентности) и ослаблении организма. К последнему относятся переохлаждения, отравления, тяжелые заболевания, нарушения питания.
Обратите внимание: в изолированном варианте трихомоноз встречается не так часто. Обычно сочетается одновременно несколько инфекций (гонорея, хламидиоз).
Врачи подчеркивают, что мочеполовая трихомониаз — это инфекционное заболевание, вызываемое простейшим Trichomonas vaginalis. Симптомы могут варьироваться: у женщин это зуд, жжение, выделения с неприятным запахом, а у мужчин — дискомфорт при мочеиспускании и выделения из уретры. Основной причиной инфекции является незащищенный половой акт с инфицированным партнером. Диагностика включает микроскопическое исследование выделений и ПЦР-тесты. Лечение обычно состоит из курса антибиотиков, таких как метронидазол или тинидазол. Врачи настоятельно рекомендуют профилактику: использование презервативов, регулярные медицинские осмотры и избегание случайных половых связей. Это поможет снизить риск заражения и распространения инфекции.

Где в организме обитает трихомонада
Из мочеиспускательного канала возбудитель заболевания может проникать в придатки яичек, предстательную железу. Некоторые исследователи сообщали в результатах своих наблюдений об обнаружении трихомонад в крови и органах человека. Они отмечали, что микроорганизмы могут быть внутритканевыми паразитами. Однако всеобщего подтверждения эта идея не получила и требует перепроверки.
Клиническая картина трихомонозных поражений неспецифична. Проявления уретрита одинаковы при разных видах возбудителя (гонококках, хламидиях, трихомонадах).
Иммунитет к трихомонозу не развивается.
Жалобы и клиника трихомониаза
Период инкубации (от заражения до проявлений) в среднем длится 10 дней, иногда – до месяца.
Мочеполовая трихомониаз — это инфекция, вызываемая простейшим организмом Trichomonas vaginalis. Люди часто отмечают, что симптомы заболевания могут варьироваться: у некоторых наблюдаются зуд и жжение в области половых органов, выделения с неприятным запахом, а у других болезнь протекает бессимптомно. Основными причинами заражения являются незащищенные половые контакты. Диагностика включает лабораторные исследования, такие как микроскопия выделений и ПЦР-тесты. Лечение обычно проводится с помощью антибиотиков, наиболее часто назначают метронидазол или тинидазол. Профилактика заключается в соблюдении правил личной гигиены, использовании презервативов и регулярных проверках на инфекции, особенно при наличии рискованных половых связей. Важно помнить, что своевременное обращение к врачу поможет избежать осложнений и распространения инфекции.

Симптомы трихомониаза у мужчин
Больной предъявляет жалобы на симптомы уретрита:
- болевые ощущения при мочеиспускании;
- учащение позывов к мочеиспусканию;
- появление выделений (слизистых, водянистых, пенистых, гнойных) из мочеиспускательного канала;
Трихомонозный процесс может распространиться на:
- предстательную железу;
- семенные пузырьки;
- придатки яичка;
- бульбоуретральные железы;
- парауретральные протоки;
- железы крайней плоти;
- мочевой пузырь;
- почечные лоханки;
- кожу головки полового члена (баланопостит);
- крайнюю плоть.
Самыми частыми осложнениями трихомоноза являются воспаление предстательной железы (простатит) и воспаление придатков яичка (эпидидимит).
Симптомы трихомониаза у женщин
При развитии трихомоноза у женщин появляются характерные жалобы:
- выделения из половых органов (обильные, часто серозно-гнойные, пенистые – характерные именно для трихомоноза);
- зуд, жжение, резь при мочеиспускании;
- отечность и гиперемия (краснота);
- возникновение эрозий в складках слизистой влагалища;
- болезненность при осмотре, при надавливании на мочеиспускательный канал – появление выделений;
- мацерированная кожа;
Часто попутно возникают остроконечные кондиломы.
Патологический процесс развивается в:
- мочеиспускательном канале;
- шейке матки;
- железах преддверия влагалища;
- полости матки;
- маточных трубах.
В железах преддверия влагалища из-за отека перекрываются выводные протоки, и образуется «ложный» абсцесс.
Если болезнь затрагивает шейку матки (эндоцервицит), то возникает отечность шейки матки, сопровождающаяся обильными выделениями. Часто образуются эрозии.
Обратите внимание: хронический вариант болезни проходит бессимптомно, или со «смазанной» картиной.

Способы определения болезни, лабораторная диагностика
Диагноз трихомониаза ставят на основании комплексного обследования пациента, включающего:
- сбор жалоб больного;
- данные осмотра;
- лабораторную диагностику.
Трихомоноз не дает никаких специфических проявлений. Симптомы одинаково характерны для большинства венерических болезней. Поэтому, в диагностике основное значение имеют данные лабораторных исследований.
Лабораторная диагностика трихомоноза
Микроскопическое исследование не всегда позволяет найти возбудителя болезни. Не всегда при ярко выраженных симптомах трихомоноза паразиты обнаруживаются в материале выделений мочеиспускательного канала. Поэтому диагностика трихомоноза должна проводиться всеми возможными лабораторными методами и повторно. Только тогда можно будет добиться положительных результатов.
Паразитический микроб ищется:
- в мазках с использованием специфических окрасок;
- в нативных препаратах.
Нативные препараты исследуются с целью определения живых трихомонад. Капля человеческих выделений помещается на предметное стекло микроскопа с двумя каплями физиологического раствора. На смесь накладывается покровное стекло и под микроскопом проводится анализ.
Исследование в «живой» капле делается при увеличениях от 100 до 400 раз. Эти разрешения позволяют хорошо различить движения микробов. Один и тот же материал рекомендуется изучать при разных разрешениях, так как размеры возбудителя могут сильно отличаться. Иногда применяется затенение, при котором паразиты становятся более заметными.
Обнаружение трихомонад необходимо проводить как можно скорее после забора материала, не допускать воздействие на него высоких или низких температур, высушивания, так как в этих условиях микроорганизмы быстро погибают.
Важно: специфическая особенность трихомонад – их движение. Одновременно можно наблюдать качание, толчкообразные рывки,
В случае отсутствия у больного возбудителей в анализе, но при выраженных клинических симптомах проводят дополнительный вариант микроскопии: первую струю мочи подвергают центрифугированию, и после появления в ней нитей, хлопьев, крошек, пипеткой отбирают эти элементы. В них часто удается обнаружить и идентифицировать возбудителя.
Необходимо соблюдать температурный режим исследования:
- пробирку с материалом держать в стакане теплой воды;
- использовать теплое предметное стекло.
Обнаружению патогенных трихомонад способствует применение методов окрашивания биоматериалов.
Наиболее распространены окраски:
- метиленовым синим (более явно проступает ядро паразита);
- по Граму (ядро приобретает фиолетовость, а жгутики и протоплазма розовый оттенок);
- по Романовскому – Гимзе (ядро становится выражено фиолетово-красным, жгутики красными, протоплазма голубоватой);
- по Лейшману (возбудители светло-синие, ядра – пурпурные).
В случаях бессимптомного течения может применяться культуральный метод.
Лечение трихомониаза
Лечиться необходимо как в случае имеющихся жалоб, так и без них, но при обнаружении возбудителя, так как бессимптомный носитель может являться источником заражения.
Профилактическая терапия носительства также необходима во избежание рецидивов болезни у пролеченных пациентов без клинических проявлений.
Применяемые для лечения большинства урогенитальных инфекций антибиотики и сульфаниламидные препараты неэффективны против трихомоноза.
В терапии используется Метронидазол (Флагил, Трихопол). Разработаны схемы приема препарата в зависимости от формы заболевания.
Обратите внимание: в 90-98 % случаев удается добиться выздоровления после курса лечения трихомоноза.
Для облегчения воспалительных процессов применяется местное воздействие промыванием мочеиспускательного канала растворами Нитрата серебра, Оксицианида ртути, Этакридином. Затем в канал вводится Осарсол с Борной кислотой и Глюкозой.
Эффективно проявляет себя Гексаметилентетрамин, Левомицетин с Борной кислотой. Эти составы вводятся в мочеиспускательный канал и во влагалище.
Для женщин рекомендуются ванночки с ромашкой, шалфеем.
Лечение трихомоноза дополняется применением Тинидазода, Нитазола.
Один из хорошо зарекомендовавших себя препаратов, «Клион Д», показан в виде влагалищных таблеток, назначаемых по 1 разу в день на протяжении 10 суток. Особо эффективен он при сочетанных инфекциях.
Критерием излеченности считаются отрицательные лабораторные анализы при неоднократных повторах в течение 2-х месяцев.
Физиотерапевтические процедуры могут применяться до полного исчезновения неприятных ощущений.
Профилактика трихомоноза
Важно помнить, что трихомоноз передается половым путем, поэтому лучшим способом защиты от заражения является сохранение чистоты отношений. Случайные, беспорядочные половые связи никогда хорошо для здоровья не заканчиваются.
Следует не забывать о правилах личной гигиены. При появлении жалоб в области половых органов необходимо сразу же обратиться к врачу, так как раннее выявление и лечение заболеваний способствует быстрому излечению и отсутствию возможности развития осложнений.
Лотин Александр, медицинский обозреватель
Вопрос-ответ
Какие симптомы при трихомониазе?
Пенистые выделения желто-зеленого цвета, воспаление слизистой оболочки гениталий, дерматит на внутренних поверхностях бедер, многочисленные очаги эрозии на стенках влагалища, болевой синдром при мочеиспускании, выраженная боль при сексуальных контактах.
Какой антибиотик убивает трихомониаз?
Лечение трихомониаза заключается в приеме антибиотиков — метронидазола (Флагил), тинидазола (Тиндамакс) или секнидазола (Солосек). Для предотвращения повторного заражения лечение должно быть проведено одновременно у обоих партнеров.
Откуда берется трихомониаз у женщин?
Основной путь передачи инфекции – половой. В 5% случаев реализуется интранатальный путь – от зараженной матери ребенку во время родов. В исключительных случаях возможно инфицирование контактно-бытовым путем – через воду для купания, мыло, полотенца.
Какой запах при трихомониазе?
Симптомами трихомониаза у женщин в острой форме могут быть: зуд, жжение и дискомфорт в области наружных половых органов учащенное и болезненное мочеиспускание изменение характера выделений из половых путей: выделения становятся желтыми или желто-зелеными, пенятся, имеют характерный зловонный запах рыбы
Советы
СОВЕТ №1
Регулярно проходите медицинские обследования, особенно если у вас есть рискованные факторы, такие как наличие нескольких половых партнеров. Это поможет своевременно выявить инфекцию и начать лечение.
СОВЕТ №2
Используйте барьерные методы контрацепции, такие как презервативы, чтобы снизить риск передачи трихомониаза и других инфекций, передающихся половым путем.
СОВЕТ №3
Обратите внимание на симптомы, такие как зуд, жжение или необычные выделения. При их появлении не откладывайте визит к врачу для диагностики и лечения.
СОВЕТ №4
Информируйте своих половых партнеров о наличии инфекции, чтобы они также могли пройти обследование и лечение. Это поможет предотвратить повторное заражение и распространение инфекции.